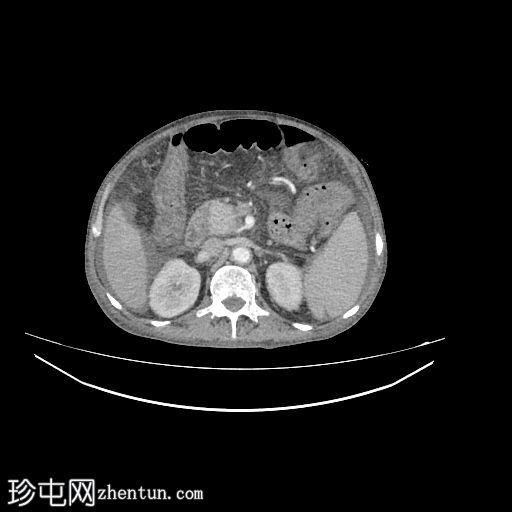
2.jpg

临床表现
患者主诉腹痛2周,巩膜黄染1周。
患者资料
年龄:50岁
性别:男
CT

轴位
平扫
轴位增强扫描
动脉期

轴位增强扫描
门静脉期

轴位增强扫描
延迟期

冠状位增强扫描
门静脉期

矢状位增强扫描
肝脏轻度肿大,未见肝内胆管扩张。近端和中段胆总管扩张至8 mm,远端突然中断,门周脂肪间隙增厚。
胰腺轻度肿大,胰周脂肪间隙增厚,符合急性胰腺炎表现。
胃大弯壁内可见一囊肿,大小为7.6 × 4.3 cm,囊壁厚度为2.5 mm,可见强化。脾门处可见另一囊肿,大小为 4.8 × 3.0 cm。
盲肠和升结肠壁水肿增厚,可能为反应性改变。
腹主动脉、脾动脉、腹腔干和肠系膜上动脉可见动脉粥样硬化改变。
中度腹水。双侧轻度胸腔积液(右侧较左侧多)。
病例讨论
本病例展示了一例急性胰腺炎并发假性囊肿形成,其中包括罕见的胃壁内假性囊肿。相关表现包括胆管炎(可能伴有远端胆总管狭窄)、中度腹水和双侧胸腔积液。此外,还可见血管粥样硬化改变和反应性肠水肿。
胃壁内假性囊肿较为罕见,是由于胰酶扩散至胃壁,导致局部积聚并伴有壁强化所致。脾门假性囊肿多见于胰腺炎的并发症。 |